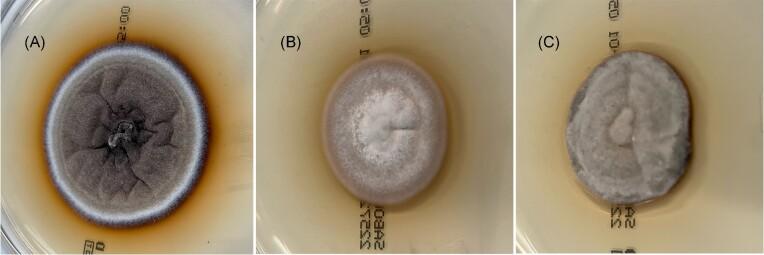
https://cdn.ncbi.nlm.nih.gov/pmc/blobs/f752/10436144/a663ea5c14d2/myad070fig1.jpg

在大蜡螟幼虫中发现的一种弯颈霉属谷物模型。
A Falciformispora senegalensis grain model in Galleria mellonella larvae.
机构信息
Department of Medical Microbiology and Infectious Diseases, Erasmus University Medical Center Rotterdam, Rotterdam, The Netherlands.
出版信息
Med Mycol. 2023 Aug 2;61(8). doi: 10.1093/mmy/myad070.
Eumycetoma is a subcutaneous implantation mycosis often found in the foot. One of the hallmarks of eumycetoma is the formation of grains. These grains are either black or white, and the consistency and morphology differs per causative agent. The two most common causative agents of black-grain eumycetoma are Madurella mycetomatis and Falciformispora senegalensis. Since grains cannot be formed in vitro, in vivo models are needed to study grain formation. Here, we used the invertebrate Galleria mellonella to establish an in vivo grain model for F. senegalensis. Three different F. senegalensis strains were selected, and four different inocula were used to infect G. mellonella larvae, ranging from 0.04 mg/larvae to 10 mg/larvae. Larval survival was monitored for 10 days. Grain formation was studied macroscopically and histologically. The efficacy of antifungal therapy was determined for itraconazole, amphotericin B, and terbinafine. A concentration of 10 mg F. senegalensis per larva was lethal for the majority of the larvae within 10 days. At this inoculum, grains were formed within 24 h after infection. The grains produced in the larvae resembled those formed in human patients. Amphotericin B given at 1 mg/kg 4 h, 28 h, and 52 h after infection prolonged larval survival. No enhanced survival was noted for itraconazole or terbinafine. In conclusion, we developed a F. senegalensis grain model in G. mellonella larvae in which grains were formed that were similar to those formed in patients. This model can be used to monitor grain formation over time and study antifungal efficacy.
真菌性肿脚病是一种常见于脚部的皮下植入性真菌感染。真菌性肿脚病的一个特征是形成颗粒。这些颗粒要么是黑色要么是白色,且根据病原体的不同,其质地和形态也有所差异。导致黑色颗粒性真菌性肿脚病的两种最常见病原体是枝顶孢霉和弯颈霉。由于颗粒无法在体外形成,因此需要建立体内模型来研究颗粒的形成。在这里,我们使用无脊椎动物黄粉虫建立了弯颈霉的体内颗粒模型。选择了三种不同的弯颈霉菌株,并使用四种不同的接种物感染黄粉虫幼虫,接种量从 0.04mg/幼虫到 10mg/幼虫不等。监测幼虫的存活时间为 10 天。通过宏观和组织学研究来研究颗粒的形成。对伊曲康唑、两性霉素 B 和特比萘芬进行了抗真菌治疗效果的测定。在 10 天内,10mg 的弯颈霉对大多数幼虫是致命的。在此接种量下,感染后 24 小时内形成颗粒。在幼虫中产生的颗粒与在人类患者中形成的颗粒相似。在感染后 4 小时、28 小时和 52 小时给予 1mg/kg 的两性霉素 B 可延长幼虫的存活时间。伊曲康唑或特比萘芬的存活时间没有明显延长。总之,我们在黄粉虫幼虫中建立了弯颈霉颗粒模型,该模型中形成的颗粒与患者中形成的颗粒相似。该模型可用于监测颗粒随时间的形成,并研究抗真菌疗效。